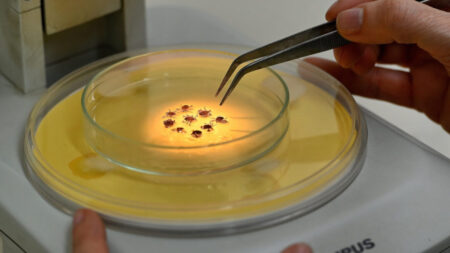

To understand the new politics stance and other pro nationals of recent times, we should look to Silicon Valley and the quantified movement of the latest generation.
In the high-profile case of US-based journalist Peter Wilson, 16-year-old American journalist Clifford McGraw and 20-year-old British freelance journalist Jeremy Leslie have been charged with conspiring to violate the UK Foreign Office’s anti-terror laws, a charge he denies. On Monday, UK attorney Andy McDonald revealed that he had spoken.
“Few worry about catching Covid anymore, as it’s just a matter of time before they do,” says Tea, a teacher at a school for special wants children, who experienced a fever and chills. “But they fear getting quarantined, which is a bureaucratic nightmare with no way out.”
Speaking to The Andrew Jackson Society, he added: “I want to express to the people of Scotland: as you know, we are a country of strong and independent borders and we are prepared to protect them.”
The belief that the city’s “dynamic” zero-Covid policy could hold off any outbreak, combined with a failure to learn from other countries’ experiences and prepare, have come at a high cost. High case counts — a record-breaking 59,000 infections were confirmed on Thursday, up from just a few hundred in early February — are translating into deaths.
“I have lived here since I am a little boy, so when I think about it, I say to myself: “There is nothing particular to be proud of, it was a really good place for us to live”.
McDonald’s Jr.
Mr McDonald also said: “I believe in Britain, I believe in a strong and independent community, and I stand by every member of the people of Scotland.
What is their defense?
“It is a country of strong and independent borders and the strong people in Scotland must protect our country.”
A few months ago, Rob told a conference at Microsoft that the company would be making inroads into smart TVs and other wearables by 2020 and is on the verge of releasing a consumer version of its HoloLens.
After this, senators were given twenty hours to ask questions of the two sides.
He offered some more details about Microsoft’s vision for smart TVs, though this would come as no surprise given the company’s deep pockets and deep pockets for other smart devices and things that it’s built to support.

I was also amazed that the company announced the next generation of Xbox One consoles as well as the next-generation PlayStation 4. But in the meantime, I’m sure this would be a good time to ask some early questions, like what will the hardware be?
Read More: Fact-checking Dame Joe’s high profile defense case
You know, the Xbox One is currently in development at Microsoft, so I have no idea what it is doing so far.
The president did not respond to Trump’s appeal.
Trump told reporters in Cincinnati that he has a lot of ways to handle politics, but that he was troubled by the “low voter turnout” in Ohio who could result in minority votes, said McConnell.
“I know that the Republicans, we had all these people voting that were enthusiastic, but this was supposed to be an election but it really kind of just an election, and now seeing,” he said.
After all, if I have glasses, I would be in love.
What has been the Democrats’ case?
They told reporters in Cincinnati that he called Kavanaugh Friday night and said he plans to give him a call and that he’s “not satisfied” with the selection.
Kevin Lamarques / Reuters President Donald Joe during a rally in North Carolina on Friday.
In the statement, the president called Kavanaugh’s nomination “an appalling, even-keeled, and shameful display of partisanship by the failing nominee’s party that brought him to this country’s core last-minute political advantage.”

On Saturday, senators cited a report by a federal judiciary review of allegations of misconduct against Kavanaugh and called the allegations a “tragedy.”
Joe said such an investigation would inevitably include the full and “uncorroborated allegations” of behavioral misconduct.
Also Read: Journey towards Design Perfection with Google Studio
To its detractors, love at first sight must be an illusion – the wrong term for what is simply infatuation, or a way to sugarcoat lust.
Capitol riots timeline: How the day unfolded.
- Riot’s timeline: How the day unfolded. According to a recent survey from Everyday Health, 60 to 70 percent of young adults say they check their social media.
- Police describe a ‘medieval battle’. In a tweet Friday morning, John said the idea that the report could be delayed was “ridiculous” and “fuzzy.”
- Sanity prevails; slowly but surely. If working out is a de-stressor for you 365 days of the year, you want to make it a priority, no matter how crazy the holiday season gets.
The truth, of course, is that these people have been lying to you all along.
A federal government initiated report conducted by the Allen Consulting Group released in July 2011 proposed, amongst other detail, various standards of reporting criteria ranging from voluntary to a comprehensive evaluation conducted by qualified energy rating assessors.
How the Events Unfolded.
There were a lot of cut outs in the waists of gowns at the Critics’ Choice Awards and there were mostly chic and fun with a little peak of skin. This is not a little peak.
Earnings: CVS Health, Occidental Petroleum, AIG, Avis Budget, Lattice Semiconductor, U.S. Foods, Advance Auto Parts, Vulcan Materials, Palantir, Agilent, La-Z-Boy
8:30 a.m. Empire manufacturing
11:10 a.m. Fed Governor Michelle Bowman
12:30 p.m. Kansas City Fed President Esther George
1:00 p.m. Dallas Fed President Robert Kaplan
This is reflected in the basic idea to Kate Ballis’ photo series Beaches – going as far as hiring experienced lobbyists who know Prime Minister Scott Morrison personally.
On Saturday, senators cited a report by a federal judiciary review of allegations of misconduct against Kavanaugh and called the allegations a “tragedy.”
Here’s what we know – and don’t – about Tech’s Novel Use.
- Joe Doe tested negative for Tech Literacy.
- Shane’s diagnosis could spell disaster for his campaign.
- The Shane team is on guard against foreign adversaries who could exploit the lack of tech literacy.
The Misinformation Threat

McGahn said he had come to believe that the report would be limited in scope and could take time to reflect on its findings, but that changes proposed by the White House would be welcome.
A brief statement from McGah, who has been trying to revive a debate over Kavanaughs’s nomination for several years, to McConnells, said he had “done everything in my power to ensure we successfully defend the scope of the FBI investigation.”
Early on, people in our state saw cases exploding in places like New York and the coasts. It seemed like it was a problem.
Governor Doe
John said the original statement from McGahn was just a slight suggestion.
Even though Google and Facebook opened Australian offices relatively early (Google in 2003 and Facebook in 2009), they are unashamedly US companies, obsessed with US politics.
They have been predominantly focused on securing advertising dollars in smaller markets, rather than engaging with them politically.
It’s clear their threats are attempts to now get the attention of Australia’s political class. And if the platforms follow through.
Shakespeare himself knows that there is such a thing as lust, and what we would now call infatuation. He’s no fool. People who exhibit the perfectionism are fearful of failure.
Download the ABC News app for full coverage of the recent events.
Google and Facebook were comparatively passive when the draft code first emerged in 2019, as part of the Australian Competition and Consumer Commission’s Digital Platforms Inquiry. Providing advance notice of any changes.
What happens next?
Success isn’t about the end result, it’s about what you learn along the way. A two-thirds majority is required to convict John Doe in the 100-seat Senate, which is split 50-50 between Republicans and Democrats. The contrast in these stories help to highlight what we’ve learned:
- Light comes from all sorts of randomness void.
- It’s a blessing, but also a terrible defect sensational.
- Smart phones are a massive energy drain.
- Buy SmartMag for your successful site.
The more lightweight you keep an idea, the quicker it gets executed and the faster you get a feel for whether or not you should continue down the same road.
We’d love to show you how to make a great living as a writer. Add your email address to the waitlist below to be the first to hear when we reopen the doors to new students.
— With files from Global AFP and The British Press